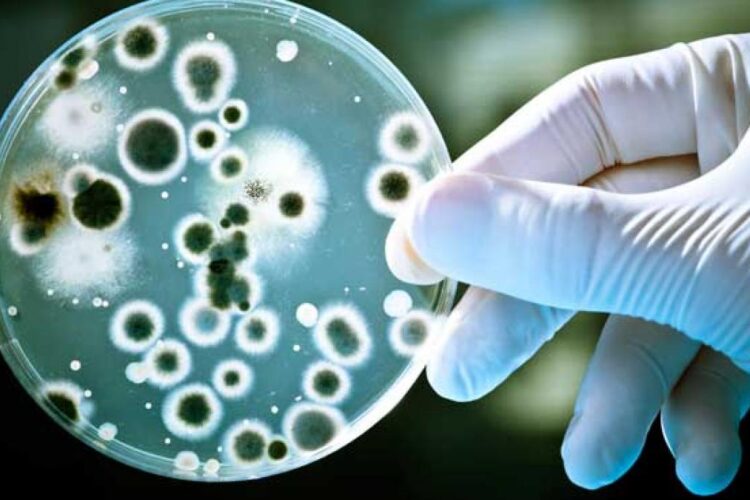
Cancerul mamar triplu negativ, aproape de un leac miraculos

Cancerul mamar triplu negativ, aproape de un leac miraculos
admin
Oamenii de știință de la Oregon Health & Science University au dezvoltat o moleculă experimentală numită SU212. Compusul vizează și dezactivează o enzimă cheie de care depind celulele canceroase pentru a crește. Studiul a fost publicat în revista Cell Reports Medicine. „Cancerul mamar triplu negativ este o formă agresivă de boală. În prezent nu există […]

România trebuie să taie 18 miliarde de lei din deficit. Bolojan, despre cele cinci provocări
admin
„Ministerul de Finanțe a publicat proiectul de buget. Ne propunem ca până la sfârșitul săptămânii să fie aprobat de Guvern și trimis Parlamentului pentru adoptare”, este începutul mesajului postat de Ilie Bolojan. Premierul susține că bugetul pentru acest an este construit într-un context economic dificil și trebuie să răspundă simultan mai multor provocări: „Guvernul trebuie […]

Profit din criză! Cât mai poate suporta România la pompă?
admin
Dar există o întrebare care devine din ce în ce mai greu de ignorat: Este justificată alinierea integrală a prețurilor internaționale atunci când o parte din combustibil provine din producție internă de țiței, cu costuri mult mai mici? Dumitru Chisăliță, președintele Asociației Energia Inteligentă, susține că în perioadele de volatilitate, când prețurile externe urcă abrupt, diferența […]

BNR cuantifică riscurile războiului din Golf asupra economiei României
admin
Banca Națională a României a găzduit conferința Rethink Romania, dedicată temelor economice de actualitate și direcțiilor de dezvoltare pentru România. Cu acestă ocazie, Cosmin Marinescu, viceguvernator BNR, a arătat că agravarea situației de securitate din Orientul Mijlociu și creșterea prețului petrolului indică riscuri de contagiune și pentru economiile Uniunii Europene. Războiul, turbulențele geopolitice și riscurile de contagiune economică […]

Primăria lui Boc a mai comis-o o dată. A cumpărat încă un rând de aparate de fitness în aer liber, de la aceeași firmă de casă
admin
Afacerea a fost adjudecată, ca de altfel toate celelalte de acest gen din trecut, de către aceeași companie comercială. Afacerea a fost atribuită la data de 25 februarie, conține 24 de loturi și costă bugetul local încă aproape 400.000 de euro. Din 2010, neîntrerupt, Primăria Municipiului Cluj-Napoca a cumpărat de la această societate comercială cu care […]
Categorii
Inscrie-te pentru a primi cele mai recente actualizari si stiri.
Linkuri Utile
© 2024 Anuntul Tau UK - Anunturi Romani UK. All rights reserved.







